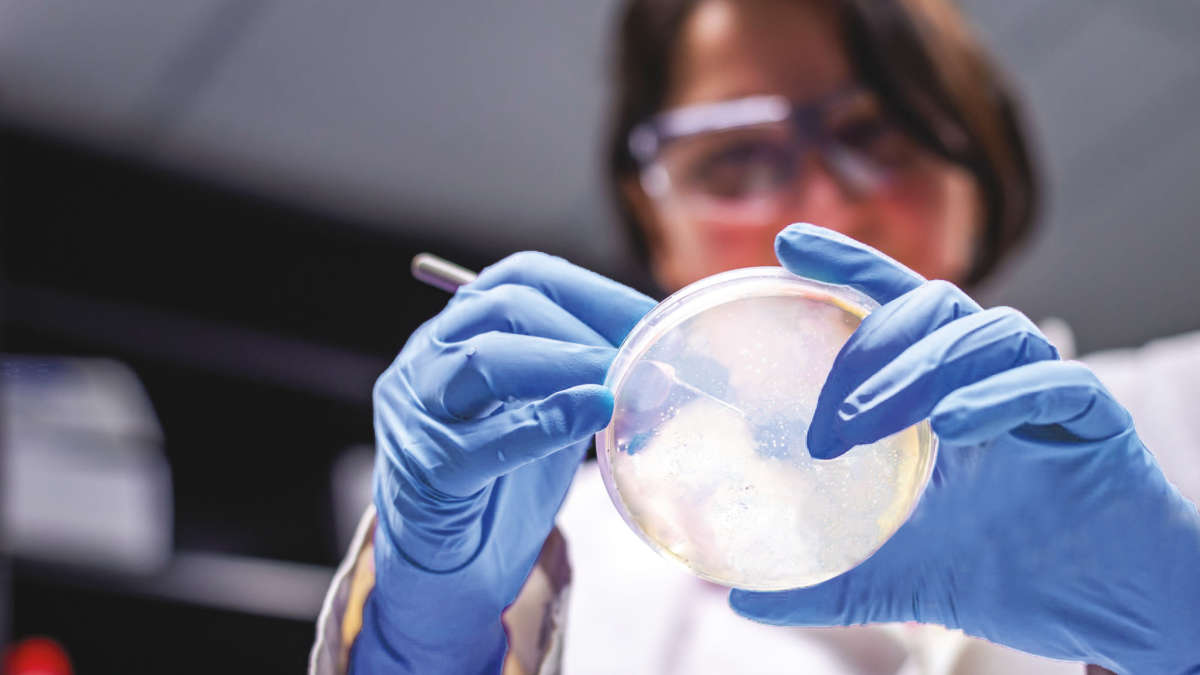

طبق یک مطالعه جدید به رهبری دانشگاه بث، مقاومت ضدمیکروبی علیرغم کاهش میزان داروهای آنتیبیوتیک تجویز شده، همچنان در محیط زیست در حال گسترش است. محققان هشدار میدهند که برای مقابله با تهدید فزاینده مقاومت ضدمیکروبی برای سلامت عمومی، به رویکردهای متعددی نیاز خواهد بود.
مقاومت ضدمیکروبی (AMR) زمانی اتفاق میافتد که باکتریها به مرور زمان تکامل مییابند و به درمان با آنتیبیوتیکها پاسخ نمیدهند. این مقاومت توسط سازمان بهداشت جهانی به عنوان یکی از بزرگترین قاتلان جهان شناخته شده است و سالانه باعث بیش از پنج میلیون مرگ میشود.
AMR میتواند از چندین طریق ایجاد شود:
• استفاده بیش از حد یا سوء استفاده از آنتیبیوتیکها برای درمان یا پیشگیری از عفونتهای باکتریایی
• استفاده از آنتیبیوتیکها در حیوانات مزرعه برای بهبود تولید گوشت
• باکتریها همچنین میتوانند با تبادل ژنها با میکروبهای مقاوم در محیط، مستقیماً مقاومت کسب کنند
محققان با تجزیه و تحلیل فاضلاب، استفاده از آنتیبیوتیکها و وجود ژنهای مرتبط با مقاومت دارویی در محیط زیست را ردیابی کردند. آنها طی دو سال در طول همهگیری کووید-۱۹ از چهار تصفیهخانه فاضلاب در جنوب غربی انگلستان نمونهبرداری کردند و آنها را با دادههای قبلی جمعآوریشده قبل از سال ۲۰۱۹ مقایسه کردند و دریافتند که با وجود کاهش فصلی در میزان آنتیبیوتیکهای تجویز شده در سالهای ۲۰۱۷-۲۰۱۹ و مقادیر کمتر داروهای آنتیبیوتیک شناساییشده در فاضلاب، هیچ کاهش متناظری در سطح ژنهای مقاومت دارویی در محیط زیست مشاهده نشد.
همچنین در سال ۲۰۲۰، کاهش قابل توجهی در آنتیبیوتیکها و ژنهای مقاومت دارویی در طول قرنطینههای ناشی از اقدامات فاصلهگذاری اجتماعی در دوران همهگیری کووید مشاهده شد که منجر به کاهش شیوع باکتریهای مقاوم شد. پس از قرنطینه، وقتی تعاملات اجتماعی افزایش یافت، هم حضور و تجویز آنتیبیوتیک و هم ژنهای AMR افزایش یافتند که نشاندهنده افزایش شیوع پاتوژن توسط افراد آلوده است.
گسترش مقاومت ضدمیکروبی تهدید بزرگی برای زندگی همگان است. انسان برای درمان عفونتهای رایج و انجام ایمن عملهای جراحی به آنتیبیوتیکها متکی است. هنگامی که ژنهای مقاومت در محیط وجود دارند، میتوانند بین باکتریها منتقل شوند و تعداد بیشتری از آنها را در برابر درمان با آنتیبیوتیکها مقاوم کنند.
محققان پیشنهاد میکنند که دولتها و سیاستگذاران باید رویکردی را برای مقابله با مقاومت دارویی اتخاذ کنند که نه فقط به نحوه استفاده از آنتیبیوتیکها در سلامت انسان، بلکه به نحوه استفاده از آنها در حیوانات و اثرات آنتیبیوتیکها بر محیط زیست نیز توجه کنند.
این مطالعه نشان میدهد که اپیدمیولوژی مبتنی بر فاضلاب، ابزاری نوآورانه و مقرونبهصرفه برای نظارت است که میتواند برای درک مصرف آنتیبیوتیکها و چگونگی گسترش ژنهای مقاوم به آنتیبیوتیک مورد استفاده قرار گیرد.